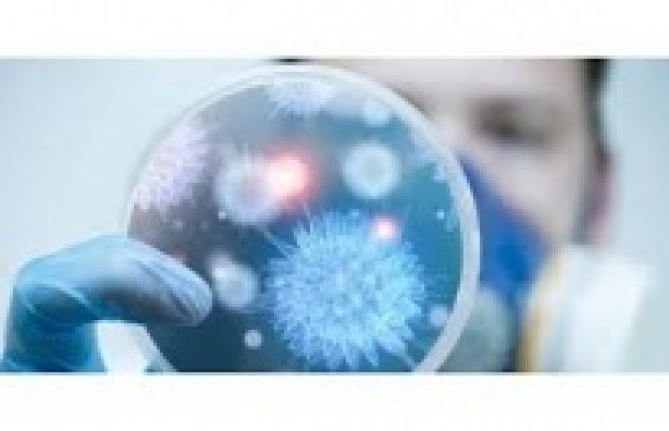
Kanserle Savaşta Umut Var: Yeni Nesil Tedaviler Kapıda”

İmmünoterapi: Vücudun Kendi Gücüyle Kanseri Yenmesi Mümkün Mü?
Son yıllarda en çok dikkat çeken tedavilerin başında immünoterapi geliyor. Bu yöntemde, hastanın bağışıklık sistemi hedefleniyor. Amaç, bağışıklık hücrelerini güçlendirerek kanserli hücreleri tanıyıp yok etmelerini sağlamak.
Özellikle akciğer, cilt (melanom), mesane ve bazı lenfoma türleri üzerinde etkili olduğu gösterilen immünoterapi, artık deneysel değil, birçok ülkede standart tedavi protokolü hâline gelmeye başladı.
“İmmünoterapi, vücudu sadece iyileştirmekle kalmıyor; aynı zamanda koruma sistemini yeniden eğitiyor. Bu, klasik tedavilerin ulaşamadığı bir başarı,” diyor Onkoloji Uzmanı Prof. Dr. Zeynep A.
Kişiye Özel Tedavi Dönemi: Genetik Harita, Yol Haritası Oluyor
Kanserin genetik bir hastalık olduğunun netleşmesiyle birlikte, her hastaya aynı tedaviyi uygulama anlayışı terk ediliyor. Kişiselleştirilmiş tıp adı verilen bu yaklaşımda, tümörün genetik yapısı analiz ediliyor ve sadece o kişiye özel bir ilaç kombinasyonu hazırlanıyor.
Özellikle meme, over (yumurtalık) ve prostat kanserlerinde genetik temelli hedefe yönelik tedaviler son yıllarda büyük başarılar sağladı.
Akıllı İlaçlar: Sadece Kanserli Hücreyi Hedef Alıyor
Klasik kemoterapi tüm hücreleri etkilerken, akıllı ilaçlar sadece tümör hücrelerini hedef alıyor. Bu sayede yan etkiler azalıyor, yaşam kalitesi artıyor.
Saç dökülmesi, mide bulantısı, bağışıklık düşüklüğü gibi yaygın kemoterapi yan etkileri, akıllı ilaç tedavilerinde çok daha az görülüyor.
Peki Bu Tedavilere Erişim Ne Kadar Mümkün?
Türkiye’de immünoterapi ve hedefe yönelik bazı tedaviler SGK kapsamında karşılanıyor, ancak her hastalık ve her evre için geçerli değil. Bu nedenle hastalar çoğu zaman ikinci görüş almak, klinik araştırmalara katılmak veya yurt dışına yönelmek zorunda kalabiliyor.
Sonuç: Umut Var, Ama Eşitlik Şart
Kanser artık tek bir düşman değil; her hastada farklı davranan, genetik düzeyde çeşitlenen bir hastalık. Ancak bilim de boş durmuyor. Yeni nesil tedaviler, artık daha az yan etkiyle daha yüksek başarı oranları sunuyor.
Gelecek yıllarda bu tedavilerin daha da yaygınlaşması ve ulaşılabilir hâle gelmesi, kanserle mücadelenin kaderini değiştirebilir.
Güncelleme Tarihi: 17 Ağustos 2025, 23:49